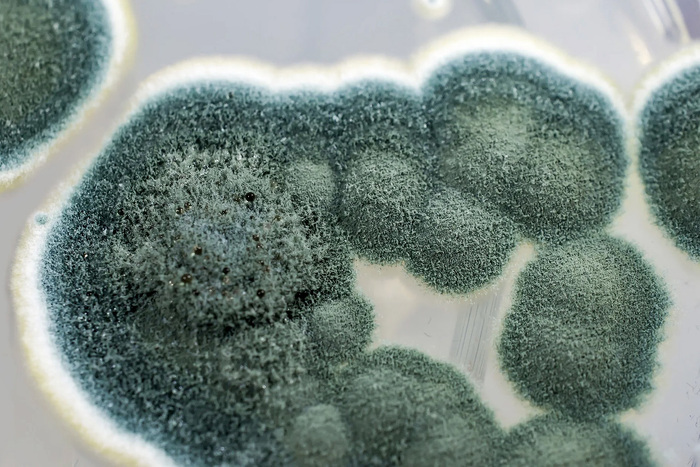
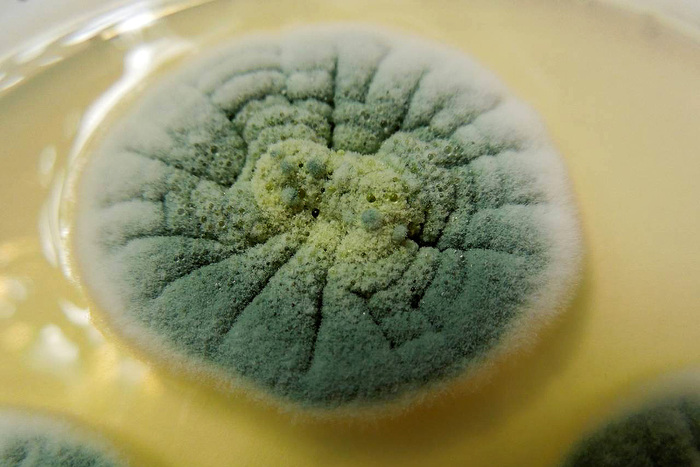

Зимний опёнок
Познавательно. Не многие знают.
Ответ на пост «Гриб, который мог спасти Пушкина»3
Бронежилет, который мог спасти Пушкина:
ТС плюс, безусловно, но увы, история не терпит сослагательного наклонения)
Всем добра)
Гриб, который мог спасти Пушкина3
Привет, мои дорогие любители необычных земных форм жизни. Сегодня у нас в гостях гриб, который, пожалуй, является самым ценным грибом на Земле, благодаря которому человечество совершило несомненный прорыв.
Но перенесёмся на почти два века назад. Восьмого февраля 1837 года пуля, выпущенная на дуэли офицером-кавалергардом Жоржем Дантесом с расстояния примерно двенадцати шагов, перебивает шейку бедра и входит в брюшную полость Александра Пушкина.
Впоследствии окажется, что рана окажется смертельной. Хотя внутренние органы и не были задеты, лишь на тонкой кишке имелся ушиб от пули размером с грош. Из брюшной полости было извлечено около половина литра крови. По сути, хороший хирург и постельный режим могли бы и в то время спасти жизнь поэту, если бы не перитонит и гангрена, против которой в те времена, увы, не было средств.
Если бы дуэль состоялась на сто лет позже, почти наверняка поэт бы выжил и ещё долгое время радовал бы мир своими новыми шедеврами. Впрочем, не факт, Пушкин был отчаянным дуэлянтом и роковая дуэль была двадцать первой на счету буйного гения.
Почти сто лет спустя, 3 сентября 1928 года, шотландский микробиолог Александр Флеминг вернулся в из отпуска, который он провёл со своей семьёй в Саффолке. Перед отъездом он оставил образцы культур стафилококка в углу лаборатории, а по приезде обнаружил, что в одной из пластин завелась плесень, которая убила популяцию бактерий вокруг себя, при этом часть популяции, которая была на расстоянии от пятна плесени чувствовала себя превосходно.
Это показалось ему забавным, и он решил изучить этот феномен подробнее. Выделил культуру грибов и стал подсаживать его в другие образцы стафилококков и других бактерий. Оказалось, что грибы убивают большинство грамположительных и часть грамотрицательных бактерий.
Позже, он идентифицировал грибы в плесени. Они относились к роду пеницилл (Penicillium). Так как Флеминг не был химиком, ему не удалось выделить само вещество, хоть он и пытался привлечь профильных специалистов, доказывая, что его открытие перевернёт мир медицины. У себя на родине он не нашёл заинтересованных лиц, и лишь спустя десять лет в США начали впервые выпускать первый в мире антибиотик – пенициллин.
Грибы рода пеницилл весьма распространены по всему миру и составляют во многих регионах до двух третей от всего видового состава грибов. Своё название они получили от латинского слова penicillus – кисть за кистевидные конидии, специфические споры некоторых родов грибов.
Что примечательно, несмотря на то, что Флеминг целых десять лет носился со своим открытием как с писаной торбой, пытаясь доказать его важность, спустя почти двадцать лет, в 1945 году он получил за открытие пенициллина Нобелевскую премию. И хотя он открыл его случайно, премию нужно было дать за то упорство, которое он применил, чтобы доказать важность своего открытия и изменить жизнь всего человечества.
В нашей стране пенициллин был впервые получен выдающимся микробиологом Зинаидой Ермольевой, в 1942 году, что позволило спасти жизни десяткам тысяч бойцов во время Великой Отечественной войны.
Ну, а у меня всё. Надеюсь вас развлёк мой небольшой очерк. Он составлен по материалам моего телеграм-канала "Планетяне". Если вам интересно каждый день узнавать о необычной природе нашей планеты, приглашаю на борт: